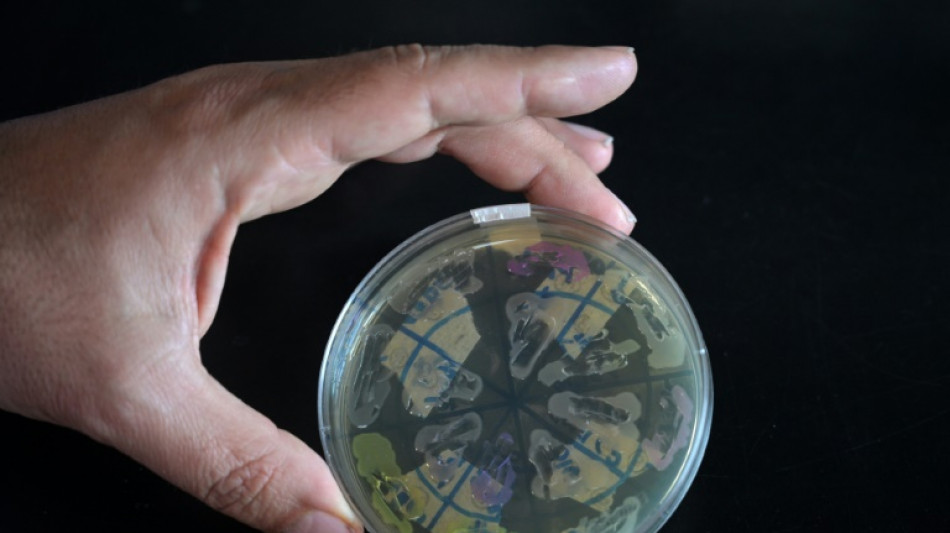
Ci&ecirc;ncia argentina 'est&aacute; &agrave; beira do colapso' devido aos cortes de financiamento de Milei

Ciência argentina 'está à beira do colapso' devido aos cortes de financiamento de Milei
O biólogo argentino Alejandro Nadra está preocupado porque teve que suspender alguns de seus experimentos sobre proteínas para prevenir doenças genéticas. Os cortes drásticos no orçamento do governo de Javier Milei estão encurralando a ciência e abrem as portas para o êxodo de pesquisadores.
“Estamos à beira do colapso”, diz Nadra em uma entrevista à AFP, cercado de caixas e tubos de ensaio na mesa abarrotada de seu laboratório na Faculdade de Ciências Exatas da Universidade de Buenos Aires, lar de três ganhadores do Prêmio Nobel de Ciências.
“Se algo não mudar, daqui a pouco tudo vai desmoronar”, adverte.
O presidente “anarco-capitalista” Javier Milei, eleito no final do ano passado em um contexto de inflação descontrolada (236% em agosto), iniciou imediatamente uma cruzada contra os gastos públicos.
Entre outras medidas, o governo começou o ano congelando os orçamentos das universidades públicas e da pesquisa e, embora tenha havido atualizações posteriores, os gastos reais com ciência e tecnologia caíram 33% em relação ao ano anterior em agosto, de acordo com o Centro Ibero-Americano de Pesquisa em Ciência, Tecnologia e Inovação.
“As pessoas estão indo embora, parando de se candidatar a bolsas de estudo ou cargos de professor porque não conseguem viver disso”, diz Nadra.
O pesquisador, que também está trabalhando no desenvolvimento de biossensores para detectar poluentes como chumbo ou arsênico na água, explica que “a descontinuidade de uma dessas linhas implica que elas não terão aplicação imediata ou de longo prazo”.
Os salários (cerca de 1,1 milhão de pesos brutos, ou cerca de US$ 1.100 pela taxa de câmbio oficial, valor em 5.992 reais na cotação atual) perderam entre 25% e 30% em termos reais em junho em comparação com o ano passado, de acordo com um relatório de setembro da rede RAICYT de institutos científicos.
- "Redução drástica" -
“Esta é a primeira vez que temos subsídios concedidos pelos quais não recebemos um peso, e não apenas não os recebemos, mas eles nos dizem 'vocês não vão recebê-los'”, disse à AFP a bióloga Edith Kordon, do laboratório que dirige no IFIBYNE, um instituto estatal dedicado à fisiologia animal, biologia molecular e neurociências.
Kordon e sua equipe estão estudando as semelhanças e diferenças entre o que acontece na glândula mamária normal e no tumor de mama para encontrar mecanismos de prevenção ou cura do câncer de mama.
“É uma pequena quantia de dinheiro que um sistema científico precisa para funcionar bem”, diz Kordon.
O ex-ministro da Ciência Lino Barañao (2007-2018) destacou recentemente que, enquanto a Argentina investe 0,31% do seu PIB em ciência, o Brasil gasta 1,21%, os Estados Unidos 3,45% e a Coreia do Sul 4,9%.
Na Argentina, a execução orçamentária em ciência e tecnologia caiu, em termos reais, 51% em relação ao ano anterior até junho, de acordo com a RAICYT.
“Nunca na história recente da Argentina houve uma redução tão drástica no orçamento científico”, disse Barañao ao jornal La Nación.
Foi o investimento estatal que permitiu, por exemplo, o desenvolvimento de trigo transgênico resistente à seca por Raquel Chan, pesquisadora do Conicet, o principal órgão científico da Argentina, com centenas de pesquisadores premiados.
Uma delas, Florencia Cayrol, acaba de ganhar o Global Research Award 2024 por seu trabalho sobre hormônios da tireoide em terapias contra o câncer.
Uma lei de 2021 estabelece um aumento escalonado no orçamento científico para 1% do PIB, mas este ano a regra não está sendo aplicada e o governo propôs revogá-la em 2025.
“Você pensa no colapso como uma grande hecatombe e, na verdade, ele já está acontecendo”, disse Kordon.
- "Precipício perigoso" -
Na semana passada, o governo ajustou o orçamento do Conicet em pouco mais de US$ 100.000 (quantia em 544,7 mil reais na cotação atual) valor que um de seus pesquisadores, o físico Jorge Aliaga, considerou “irrelevante” para as necessidades do setor. “Isso não muda nada”, disse ele à AFP.
Em março, um grupo de 68 cientistas renomados expressou em uma carta pública sua preocupação sobre “como o sistema argentino de ciência e tecnologia está se aproximando de um precipício perigoso”.
Ao justificar os cortes, Milei mirou nos “supostos cientistas e intelectuais, que acreditam que ter um diploma acadêmico os torna seres superiores”.
“Se você acha que sua pesquisa é tão útil, eu o convido a entrar no mercado como qualquer outro filho do vizinho, fazer sua pesquisa, publicar um livro e ver se as pessoas estão interessadas ou não, em vez de se esconder atrás da força coercitiva do Estado”, disse ele.
“O que ele disse é um absurdo”, argumentou Alejandro Nadra, ”historicamente, todos os desenvolvimentos tecnológicos foram total ou amplamente alavancados pelo Estado.
O apoio do Estado possibilitou tudo, desde o desenvolvimento de vacinas até antibióticos, como a descoberta da penicilina por Alexander Fleming no século passado.
T.Salinas--LGdM



